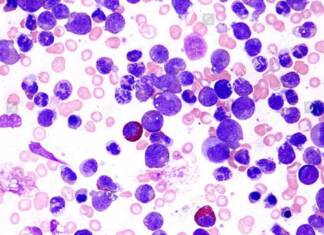
Tratamiento de la leucemia: especialistas analizan un cambio de paradigma para vencer la enfermedad

VIVO SHOW
REGIÓN
Lanzan «Andamios» en Tanti: un nuevo programa de apoyo escolar y acompañamiento para estudiantes
Con el objetivo de fortalecer el aprendizaje de niños y jóvenes de la localidad, se anunció la puesta en marcha del Programa Andamios. Se trata de un espacio de acompañamiento educativo y comunitario diseñado...
Noche de música y encuentro en el Microcine Sala Caraffa de La Cumbre
El Microcine Sala Caraffa de La Cumbre fue escenario de una velada especial con la presentación de “Vuelve Agosto”, el espectáculo del músico José Alba.
Entre canciones, relatos y una atmósfera íntima, el artista logró...
Capilla del Monte impulsa su perfil gastronómico con el “Mes de la Paella y...
La propuesta reúne a 14 restaurantes con menús especiales y busca atraer visitantes durante el otoño
Capilla del Monte volvió a poner en marcha la segunda edición de “Abril, Mes de la Paella y los...
DEPORTES VIVO
Tratamiento de la leucemia: especialistas analizan un cambio de paradigma para vencer la enfermedad
En el marco del 6º Congreso del Grupo Latinoamericano de Leucemia Linfocítica Crónica (LAG-CLL Meeting 2026), que se desarrolla este jueves y viernes en la provincia de Mendoza, investigadores y hematólogos internacionales presentan avances...
Buscan una familia para Maia: el Registro Único de Adopciones lanzó una convocatoria abierta...
El Registro Único de Adopciones (RUA) de Córdoba ha iniciado una búsqueda especial. Se trata de una convocatoria dirigida a personas, familias o parejas radicadas en cualquier punto de la provincia que se sientan...
Solidaridad por Cristina Loza: la escritora cordobesa vende sus libros para costear una cirugía...
La reconocida escritora cordobesa Cristina Loza atraviesa un difícil presente tras sufrir un grave accidente durante un viaje familiar en Costa Rica.
Ante la falta de cobertura médica en la región donde se encontraba y...
Arranca el jury por el caso Dalmasso: juzgan a tres fiscales por presunto mal...
El próximo martes 21 de abril comenzará el debate oral y público ante el Jurado de Enjuiciamiento de Magistrados y Funcionarios, en el marco del proceso que evaluará la actuación de los fiscales Javier...
Furor y polémica en Chubut: una carnicería agotó su stock de carne de burro...
Una propuesta disruptiva ha sacudido el mercado gastronómico en el sur del país. Lo que comenzó como una alternativa productiva ante las dificultades de la cría tradicional en la Patagonia, terminó convirtiéndose en un...
+ NOTICIAS
TURISMO Y NEGOCIOS
#PhoTortul 3939
"El tránsito somos todos"
Uruguay y Olsacher - #VCP
Viernes 17 de abril de 2026
La foto engaña. El zoom aplana la escena, ordena el caos; parece una avenida cualquiera en una mañana cualquiera. Pero no. Acá, en la Uruguay casi...